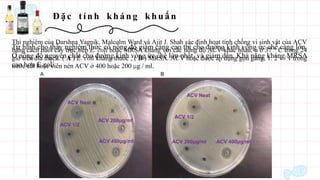
Đ ặ c t í n h kh á n g kh u ẩ n
Thí nghiệm của Darshna Yagnik, Malcolm Ward và Ajit J. Shah xác định hoạt tính chống vi sinh vật của ACV
bằng cách nuôi cấy trực tiếp E. coli hoặc MRSA kháng với các nồng độ ACV khác nhau, ủ ở 37 ° C trong 24
giờ trên đĩa thạch. ( A ) E. coli kháng thuốc ; ( B ) MRSA. ACV hoặc được áp dụng gọn gàng, 1: 2 v / v trong
nước cất hoặc viên nén ACV ở 400 hoặc 200 μg / ml.
Từ hình cho thấy nghiệm thức có nồng độ giấm càng cao thì cho đường kính vòng ức chế càng lớn.
Ở nồng đồ nguyên chất cho đường kính vòng ức chế lớn nhất, và giảm dần. Khả năng kháng MRSA
cao hơn E.coli

Giấm có nhiều lợi ích sức khỏe, bao gồm hoạt động chống oxy hóa, kháng khuẩn và tác dụng chống đái tháo đường. Các hợp chất trong giấm giúp giảm stress oxy hóa, ngăn chặn sự phát triển của vi khuẩn và cải thiện độ nhạy insulin. Hơn nữa, giấm còn có khả năng giảm béo phì nội tạng và hỗ trợ điều chỉnh huyết áp.






![Hoạt động chống oxy của giấm
Việc xác định khả năng chống oxy hóa của giấm thường được thực hiện
bằng các phương pháp như:
(1) Thử nghiệm loại bỏ gốc DPPH (gốc 2,2-diphenyl-1-pic-rylhydrazyl),
bao gồm giảm độ hấp thụ của thuốc thử DPPH (màu tím chuyển sang
màu vàng) được đo ở bước sóng 517 nm sau khi phản ứng với các chất
chống oxy hóa mẫu.
(2) Hoạt tính loại bỏ gốc ABTS [2,2'-azino-bis- (3-ethylbenzthiazoline-6-
sulfonic acid) cation gốc; ABTS+], bao gồm phép đo độ hấp thụ của gốc
xanh lục-xanh lam ở bước sóng 734 nm sau khi phản ứng với mẫu.
(3) Khả năng chống oxy hóa khử cốc (CUPRAC), bao gồm phản ứng của chất
chống oxy hóa mẫu với Cu2+ và neocuproine (2,9-dimethyl-1,10-phenanthroline;
một hợp chất hữu cơ dị vòng, tạo chelat) và phép đo độ hấp thụ ở bước sóng
450nm. Sử dụng axit L-ascorbic hoặc Trolox tương ứng là các hợp chất chống
oxy hóa tham chiếu.
(4) Sử dụng thử nghiệm công suất chống oxy hóa khử sắt (FRAP), bao gồm việc
khử sắt (Fe3+) thành sắt đen (Fe2+) bằng các chất chống oxy hóa mẫu và đo độ
hấp thụ của màu xanh lam phát triển ở 594 nm. Khả năng chống oxy hóa được
xác định bằng cách sử dụng đường chuẩn Fe2+ và được biểu thị bằng giá trị
Fe2+ đương lượng (μM) hoặc FRAP.](https://image.slidesharecdn.com/gim5-211219134302/85/l-i-ich-s-c-kh-e-c-a-gi-m-7-320.jpg)